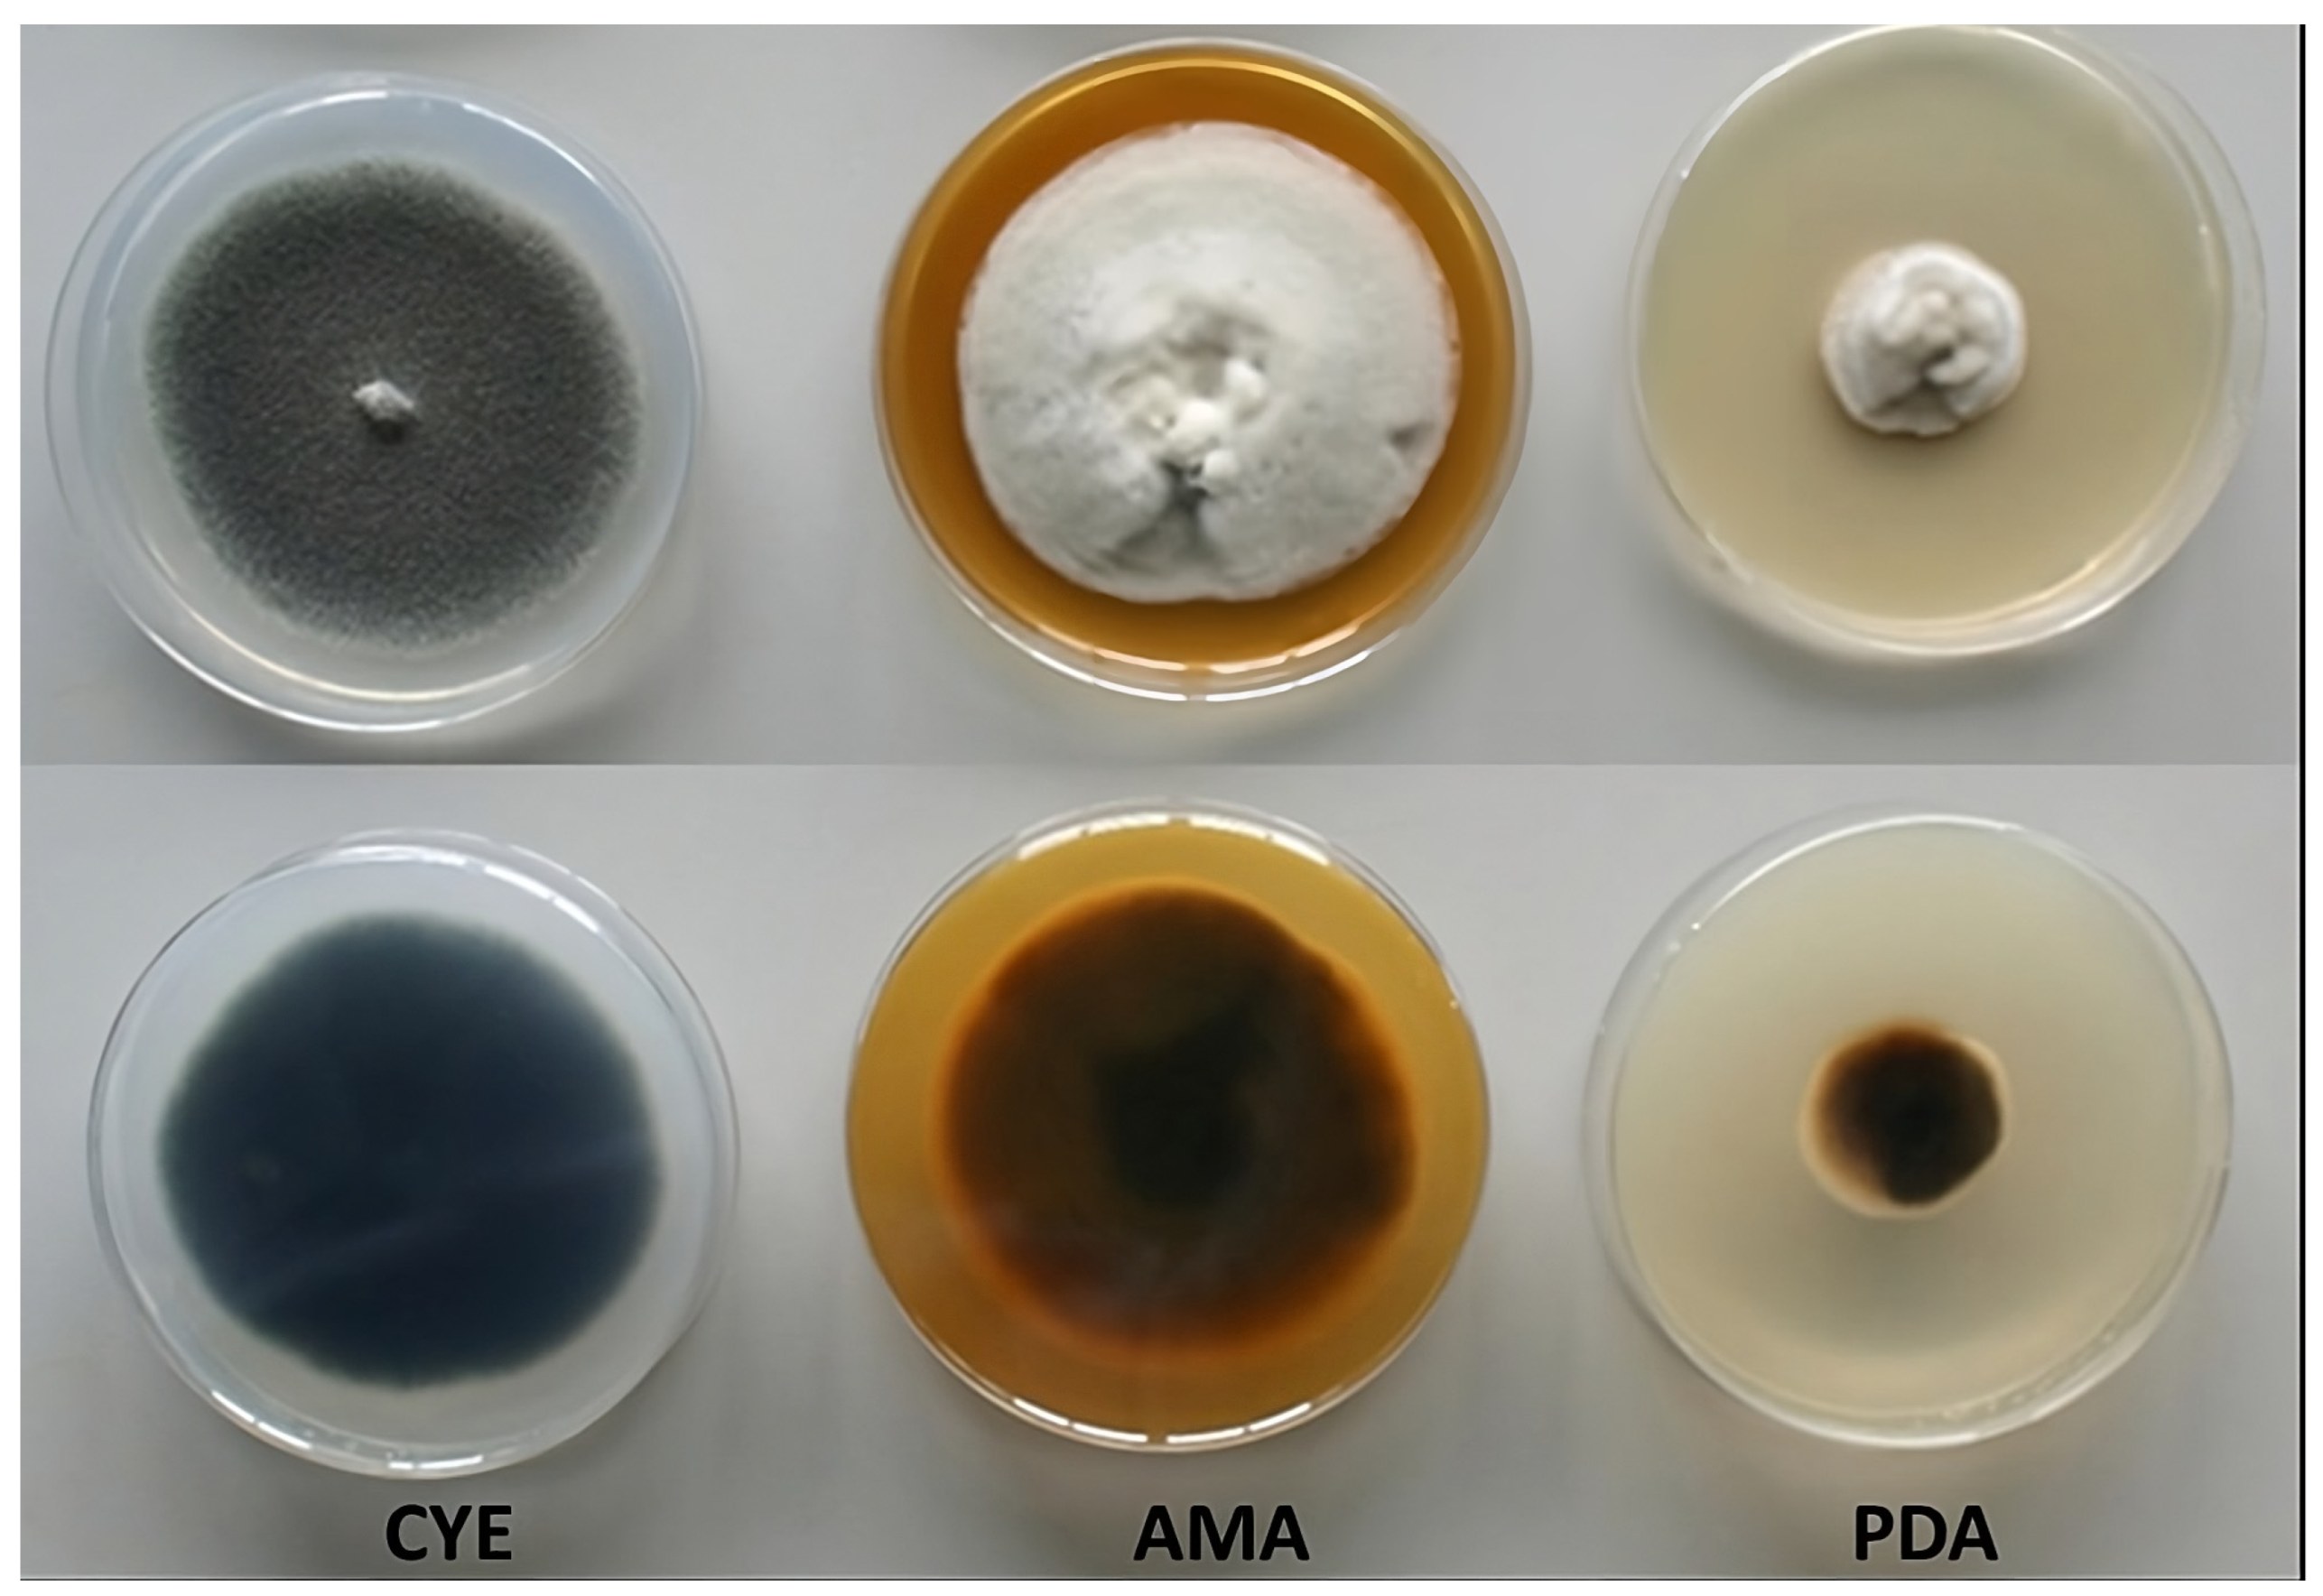

Microbiological Aspects and Enzymatic Characterization of Curvularia kusanoi L7: Ascomycete with Great Biomass Degradation Potentialities
Abstract
1. Introduction
2. Materials and Methods
2.1. C. kusanoi L7 Growth on Different Culture Media
2.2. Growth on 2% Cellulose Agar
2.3. Growth on Tannic Acid
2.4. Determination of C. kusanoi L7 Carbon Mineralization of Raw Wheat Straw by Gas Spectroscopy—Total Attenuated Reflection Infrared Spectroscopy with Fourier Transform (ATR-FT-IR) Assisted
2.5. Lignocellulolytic Capacity of the C. kusanoi L7 Strain in Solid Submerged Fermentation of Sugarcane Bagasse and in Wheat Bran
2.6. Statistical Analysis
3. Results
3.1. C. kusanoi L7 Growth on Different Culture Media
3.2. Growth of C. kusanoi L7 in Medium with 2% Cellulose and on Tannic Acid
3.3. Determination of C. kusanoi L7 Carbon Mineralization of Raw Wheat Straw by Gas Spectroscopy–ATR-FT-IR Assisted
3.4. Lignocellulolytic Capacity of the C. kusanoi L7 Strain in Solid Submerged Fermentation of Sugarcane Bagasse and in Wheat Bran
4. Discussion
5. Conclusions
Supplementary Materials
Author Contributions
Funding
Institutional Review Board Statement
Informed Consent Statement
Data Availability Statement
Acknowledgments
Conflicts of Interest
References
- Reeta, R.; Singhania, M.; Adsul, A.; Pandey, A. Cellulases. In Current Developments in Biotechnology and Bioengineering; Elsevier: Amsterdam, The Netherlands, 2017; pp. 73–101. [Google Scholar]
- Oliva-Taravilla, A.; Tomás-Pejó, E.; Demuez, M.; González-Fernández, C.; Ballesteros, M. Phenols and lignin: Key players in reducing enzymatic hydrolysis yields of steam-pretreated biomass in presence of laccase. J. Biotechnol. 2016, 218, 94–101. [Google Scholar] [CrossRef] [PubMed]
- Oliva-Taravilla, A.; Tomás-Pejó, E.; Demuez, M.; González-Fernández, C.; Ballesteros, M. Inhibition of cellulose enzymatic hydrolysis by laccase-derived compounds from phenols. Biotechnol. Prog. 2015, 31, 700–706. [Google Scholar] [CrossRef] [PubMed]
- Manici, L.M.; Caputo, F.; De Sabata, D.; Fornasier, F. The enzyme patterns of Ascomycota and Basidiomycota fungi reveal their different functions in soil. Appl. Soil Ecol. 2024, 196, 105323. [Google Scholar] [CrossRef]
- Uber, T.M.; Backes, E.; Saute, V.M.S.; da Silva, B.P.; Corrêa, R.C.G.; Kato, C.G.; Seixas, F.A.V.; Bracht, A.; Peralta, R.M. 2023. Chapter 6—Enzymes from basidiomycetes—Peculiar and efficient tools for biotechnology. In Biotechnology of Microbial Enzymes, 2nd ed.; Brahmachari, G., Ed.; Academic Press: Cambridge, MA, USA, 2023; pp. 129–164. ISBN 9780443190599. [Google Scholar] [CrossRef]
- Hamed, A.A.; Abd-Elaziz, A.M.; Ghanem, M.M.; ElAwady, M.E.; Abdel-Aziz, M.S. Production of laccase enzyme from Curvularia lunata MY3: Pu-rification and characterization. Folia Microbiol. 2024, 69, 221–234. [Google Scholar] [CrossRef]
- Teather, R.M.; Wood, P.J. Use of Congo red-polysaccharide interactions in enumeration and characterization of cellulolytic bacteria from the bovine rumen. Appl. Environ. Microbiol. 1982, 43, 777–780. [Google Scholar] [CrossRef]
- Nobles, M.K. Cultural characters as a guide to the taxonomy and phylogeny of the polyporaceae Detection of poliphenoloxidase in fungi. Can. J. Bot. 1958, 36, 883–926. [Google Scholar] [CrossRef]
- Yoon, L.W.; Ang, T.N.; Ngoh, G.C.; Chua, A.S.M. Fungal solid-state fermentation and various methods of enhancement in cellulase production. Biomass Bioenergy 2014, 67, 319–338. [Google Scholar] [CrossRef]
- Adney, B.; Baker, J. Measurement of Cellulase Activities. Laboratory Analytical Procedure (LAP); Technical Report NREL/TP-510-42628; National Renewable Energy Laboratory: Golden, CO, USA, 2008. [Google Scholar]
- Mandels, M.; Andreotti, R.E.; Roche, C. Measurement of sacarifying cellulose. Biotechnol. Bioeng. Symp. 1976, 6, 1471–1493. [Google Scholar]
- Perna, V.; Agger, J.W.; Holck, J.; Meyer, A.S. Multiple Reaction Monitoring for quantitative laccase kinetics by LC-MS. Sci. Rep. 2018, 8, 8114. [Google Scholar] [CrossRef]
- Casciello, C.; Tonin, F.; Berini, F.; Fasoli, E.; Marinelli, F.; Pollegioni, L.; Rosini, E. A valuable peroxidase activity from the novel species Nonomuraea gerenzanensis growing on alkali lignin. Biotechnol. Rep. 2017, 13, 49–57. [Google Scholar] [CrossRef]
- Duncan, D.B. Multiple Range and Multiple F Tests. Biometrics 1955, 11, 1–42. [Google Scholar] [CrossRef]
- Di Rienzo, J.A.; Casanoves, F.; Balzarini, M.G.; Gonzalez, L.; Tablada, M.; Robledo, C.W. InfoStat; Version 1; InfoStat, FCA, Universidad Nacional de Córdoba: Córdoba, Argentina, 2012. [Google Scholar]
- Gado, H.; Salem, A.; Robinson, P.; Hassan, M. Influence of exogenous enzymes on nutrient digestibility, extent of ruminal fermentation as well as milk production and composition in dairy cows. Anim. Feed. Sci. Technol. 2009, 154, 36–46. [Google Scholar] [CrossRef]
- Koyani, R.D.; Sanghvi, G.V.; Sharma, R.K.; Rajput, K.S. Contribution of lignin degrading enzymes in decolourisation and degradation of reactive textile dyes. Int. Biodeterior. Biodegrad. 2013, 77, 1–9. [Google Scholar] [CrossRef]
- Torres, A.M.; Quintero, J.C.; Atehortua, L. Efecto de nutrientes sobre la producción de biomasa del hongo me-dicinal Ganoderma lucidum. Rev. Colomb. Biotechnol. 2011, 13, 103–109. [Google Scholar]
- Ahmad, S.; Kothari, R.; Shankarayan, R.; Tyagi, V.V. Temperature dependent morphological changes on algal growth and cell surface with dairy industry wastewater: An experimental investigation. 3 Biotech 2020, 10, 24. [Google Scholar] [CrossRef]
- Khiralla, A.; Spina, R.; Saliba, S.; Laurain-Mattar, D. Diversity of natural products of the genera Curvularia and Bipolaris. Fungal Biol. Rev. 2018, 33, 101–122. [Google Scholar] [CrossRef]
- Piontelli, E. Especies oportunistas de importancia clínica de los géneros Bipolaris Shoemaker y Curvularia Boedijn. Bol. Micol 2015, 30, 40–63. [Google Scholar] [CrossRef]
- Maciel, A.S.; Araújo, J.V.; Campos, A.K. Viabilidade sobre larvas infectantes de Ancylostoma spp dos fungos nematófagos Arthrobotrys robusta, Duddingtonia flagrans e Monacrosporium thaumasium após esporulação em dife-rentes meios de cultura. Rev. Bras. De Parasitol. Veterinária 2006, 15, 182–187. [Google Scholar]
- Rosyida, V.T.; Indrianingsih, A.W.; Maryana, R.; Wahono, S.K. Effect of Temperature and Fermentation Time of Crude Cellulase Production by Trichoderma Reesei on Straw Substrate. Anim. Feed. Sci. Technol. 2015, 65, 368–371. [Google Scholar] [CrossRef]
- Valiño, E.C. Fermentación en Estado Sólido Del Bagazo Por Hongos Conidiales Productores de Celulasa Tesis en Opción al Grado de Doctor en Ciencia; Instituto Superior Agropecuario de la Habana: Havana, Cuba, 1999. [Google Scholar]
- Reid, I.D. Biodegradation of lignin. Can. J. Bot. 1995, 73 (Suppl. S1), 1011–1018. [Google Scholar] [CrossRef]
- Sowmya, H.V.; Ramalingappa, B.; Nayanashree, G.; Thippeswamy, B.; Krishnappa, M. Polyethylene Degra-dation by Fungal Consortium. Int. J. Environ. Res. 2015, 9, 823–830. [Google Scholar]
- Lucas, E.M.; Abreu, L.M.; Marriel, I.E.; Pfenning, L.H.; Takahashi, J.A. Phthalates production from Curvularia senegalensis (Speg.) Subram, a fungal species associated to crops of commercial value. Microbiol. Res. 2008, 163, 495–502. [Google Scholar] [CrossRef]
- Fundación Española Para el Desarrollo de la Nutrición Animal (FEDNA). Paja de Cereales y Cebada. 2019. Available online: http://www.fundacionfedna.org/ingredientes_para_piensos/paja-de-cereales-trigo-y-cebada (accessed on 10 September 2024).
- Martínez, C.; Balcázar, E.; Dantán, E.; Folch, J. Celulasas fúngicas: Aspectos biológicos y aplicaciones en la in-dustria energética. Rev. Latinoam. Microbiol. 2008, 50, 119–131. [Google Scholar]
- Valiño, E.C.; Savón, L.; Elías, A.; Rodríguez, M.; Albelo, N. Nutritive value improvement of seasonal legumes Vigna unguiculata, Canavalia ensiformis, Stizolobium niveum, Lablab purpureus, through processing their grains by Trichoderma viride M5-2 cellulases. Cuba. J. Agric. Sci. 2015, 49, 81. [Google Scholar]
- Valiño, E.C.; Elías, A.; Torres, V.; Carrasco, T.; Albelo, N. Improvement of sugarcane bagasse composition by the strain Trichoderma viride M5-2 in a solid-state fermentation bioreactor. Cuba. J. Agric. Sci. 2004, 38, 145. [Google Scholar]
- Vázquez, M.A.; Cabrera, E.C.V.; Aceves, M.A.; Mallol, J.L.F. Cellulolytic and ligninolytic potential of new strains of fungi for the conversion of fibrous substrates. Biotechnol. Res. Innov. 2019, 3, 177–186. [Google Scholar] [CrossRef]
- Jaramillo, A.C.; Cobas, M.; Hormaza, A.; Sanromán, M. Degradation of Adsorbed Azo Dye by Solid-State Fermentation: Improvement of Culture Conditions, a Kinetic Study, and Rotating Drum Bioreactor Performance. Water Air Soil Pollut. 2017, 228, 205. [Google Scholar] [CrossRef]
- Singh, P.; Sulaiman, O.; Hashim, R.; Peng, L.C.; Singh, R.P. Evaluating biopulping as an alternative application on oil palm trunk using the white-rot fungus Trametes versicolor. Int. Biodeterior. Biodegrad. 2013, 82, 96–103. [Google Scholar] [CrossRef]
- Daâssi, D.; Zouari-Mechichi, H.; Frikha, F.; Rodríguez-Couto, S.; Nasri, M.; Mechichi, T. Sawdust waste as a low-cost support-substrate for laccases production and adsorbent for azo dyes decolorization. J. Environ. Health Sci. Eng. 2016, 14, 1–12. [Google Scholar] [CrossRef]
- Bazanella, G.C.D.; de Souza, D.F.; Castoldi, R.; Oliveira, R.F.; Bracht, A.; Peralta, R.M. Production of laccase and man-ganese peroxidase by Pleurotus pulmonarius in solid-state cultures and application in dye decolorization. Folia Microbiol. 2013, 58, 641–647. [Google Scholar] [CrossRef]
- Neifar, M.; Jaouani, A.; Ellouze-Ghorbel, R.; Ellouze-Chaabouni, S.; Penninckx, M.J. Effect of culturing processes and copper addition on laccase production by the white-rot fungus Fomes fomentarius MUCL 35117. Lett. Appl. Microbiol. 2009, 49, 73–78. [Google Scholar] [CrossRef] [PubMed]
- Wang, F.; Xu, L.; Zhao, L.; Ding, Z.; Ma, H.; Terry, N. Fungal Laccase Production from Lignocellulosic Agricultural Wastes by Solid-State Fermentation: A Review. Microorganisms 2019, 7, 665. [Google Scholar] [CrossRef] [PubMed]
- Sumathi, T.; Viswanath, B.; Lakshmi, A.S.; SaiGopal, D.V.R. Production of Laccase by Cochliobolussp. Isolated from Plastic Dumped Soils and Their Ability to Degrade Low Molecular Weight PVC. Biochem. Res. Int. 2016, 2016, 9519527. [Google Scholar] [CrossRef]
- Janusz, G.; Czuryło, A.; Frąc, M.; Rola, B.; Sulej, J.; Pawlik, A.; Siwulski, M.; Rogalski, J. Laccase production and metabolic diversity among Flammulina velutipes strains. World J. Microbiol. Biotechnol. 2015, 31, 121–133. [Google Scholar] [CrossRef]
- Moreno, A. Estudio de Enzimas Oxidorreductasas en Latransformación de Biomasa Lignocelulósica en Biocombustibles. Ph.D. Thesis, Universidad Complutense de Madrid, Madrid, Spain, 2013; pp. 1–247. Available online: http://hdl.handle.net/10839/2130 (accessed on 22 September 2024).
- Salvachúa, D.; Prieto, A.; Vaquero, M.E.; Martínez, T.; Martínez, M.J. Sugar recoveries from wheat straw following treatments with the fungus Irpex lacteus. Bioresour. Technol. 2013, 131, 218–225. [Google Scholar] [CrossRef] [PubMed]

| Cellulolytic Activity (IU/mL) | Fermentation Time (Hours) | |||||||
|---|---|---|---|---|---|---|---|---|
| 24 | 48 | 72 | 96 | 120 | 144 | 168 | SE and p | |
| Endo-1,4-β-glucanase | 2.87 g | 2.11 e | 2.41 f | 1.90 d | 1.28 c | 1.13 b | 0.977 a | ±0.22 p = 0.0004 |
| Exo-1,4-β-glucanase | 0.35 b | 0.90 d | 0.61 c | 0.018 a | 0.008 a | 0.003 a | 0.0006 a | ±0.36 p = 0.0021 |
| Cellulolytic Activity (IU/mL) | Fermentation Time (Hours) | |||||||
|---|---|---|---|---|---|---|---|---|
| 24 | 48 | 72 | 96 | 120 | 144 | 168 | SE and p | |
| Endo-1,4-β-glucanase | 0.608 e | 0.402 d | 0.921 f | 0.185 c | 0.098 b | 0.035 a | 0.029 a | ±0.022 p = 0.0003 |
| Exo-1,4-β-glucanase | 0.55 c | 0.24 b | 0.20 b | 0.08 a | 0.07 a | 0.07 a | 0.03 a | ±0.011 p = 0.045 |
| Ligninolytic Activity (IU/mL) | Fermentation Time (Hours) | |||||||
|---|---|---|---|---|---|---|---|---|
| 48 | 72 | 96 | 120 | 144 | 168 | 192 | SE and p | |
| Laccase | - | 0.13 a | 0.30 b | 0.38 b | 0.51 d | 0.84 e | 0.49 c | ±0.61 p = 0.0012 |
| Peroxidase | - | - | 0.21 c | 0.11 b | 0.002 a | - | - | ±0.36 p = 0.043 |
| Ligninolytic Activity (IU/mL) | Fermentation Time (Hours) | |||||||
|---|---|---|---|---|---|---|---|---|
| 48 | 72 | 96 | 120 | 144 | 168 | 192 | SE and p | |
| Laccase | - | 0.24 a | 0.46 b | 0.53 c | 0.81 d | 1.64 e | 0.6 c | ±0.44 p = 0.0023 |
| Peroxidase | - | - | 0.18 c | 0.06 b | 0.002 a | - | - | ±0.36 p = 0.0034 |
Disclaimer/Publisher’s Note: The statements, opinions and data contained in all publications are solely those of the individual author(s) and contributor(s) and not of MDPI and/or the editor(s). MDPI and/or the editor(s) disclaim responsibility for any injury to people or property resulting from any ideas, methods, instructions or products referred to in the content. |
© 2024 by the authors. Licensee MDPI, Basel, Switzerland. This article is an open access article distributed under the terms and conditions of the Creative Commons Attribution (CC BY) license (https://creativecommons.org/licenses/by/4.0/).
Share and Cite
Alberto Vazquez, M.; Saa, L.R.; Valiño, E.; Torta, L.; Laudicina, V.A. Microbiological Aspects and Enzymatic Characterization of Curvularia kusanoi L7: Ascomycete with Great Biomass Degradation Potentialities. J. Fungi 2024, 10, 807. https://doi.org/10.3390/jof10120807
Alberto Vazquez M, Saa LR, Valiño E, Torta L, Laudicina VA. Microbiological Aspects and Enzymatic Characterization of Curvularia kusanoi L7: Ascomycete with Great Biomass Degradation Potentialities. Journal of Fungi. 2024; 10(12):807. https://doi.org/10.3390/jof10120807
Chicago/Turabian StyleAlberto Vazquez, Maryen, Luis Rodrigo Saa, Elaine Valiño, Livio Torta, and Vito Armando Laudicina. 2024. "Microbiological Aspects and Enzymatic Characterization of Curvularia kusanoi L7: Ascomycete with Great Biomass Degradation Potentialities" Journal of Fungi 10, no. 12: 807. https://doi.org/10.3390/jof10120807
APA StyleAlberto Vazquez, M., Saa, L. R., Valiño, E., Torta, L., & Laudicina, V. A. (2024). Microbiological Aspects and Enzymatic Characterization of Curvularia kusanoi L7: Ascomycete with Great Biomass Degradation Potentialities. Journal of Fungi, 10(12), 807. https://doi.org/10.3390/jof10120807

